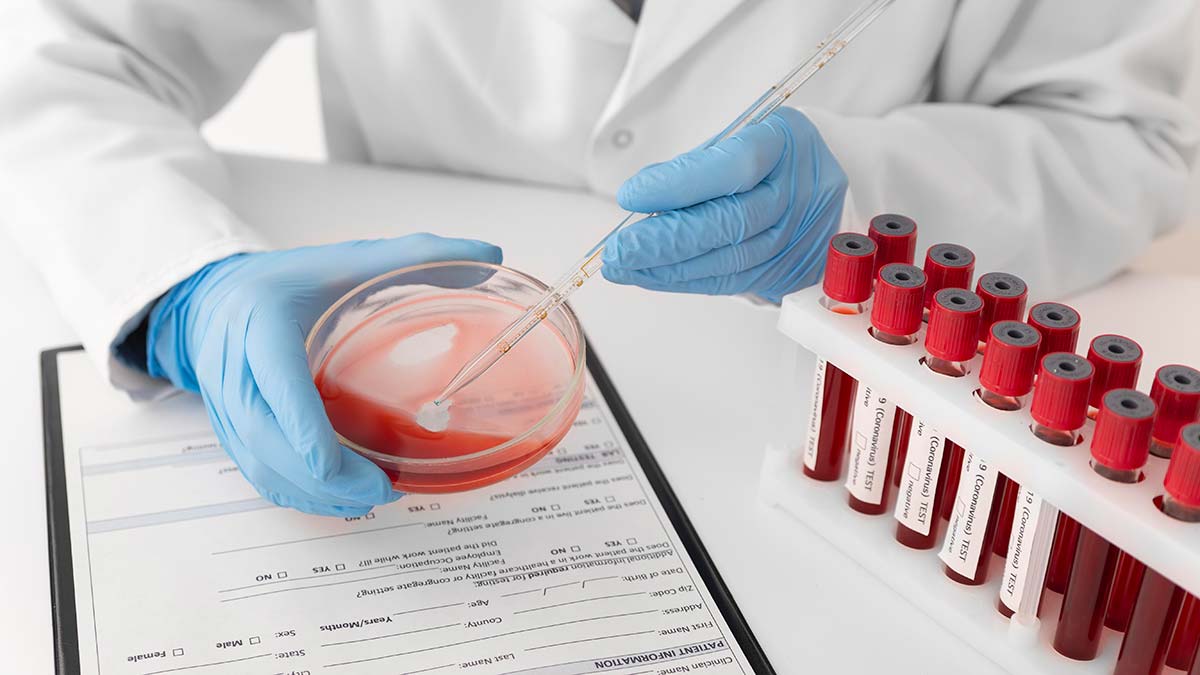
Koronavirüs tablosu 10 Şubat 2022

Sağlık Bakanlığı, ‘Koronavirüs tablosu 10 Şubat 2022’ verilerini açıkladı.
Son 24 saatte yapılan 450 bin 044 testte 98 bin 563 vaka tespit edildi. 264 kişi hayatını kaybederken, 87 bin 932 kişinin de tedavisi ve karantinası sona erdi.

Sağlık Bakanlığı’nın açıkladığı ‘Günlük Kovid- 19 Tablosu‘ verilerine göre; son 24 saatte yapılan 450 bin 044 testte 98 bin 602 vaka tespit edildi. Koronavirüs nedeniyle 264 kişi hayatını kaybederken, 87 bin 932 kişinin de tedavisi ve karantinası sona erdi. 18 yaş ve üzeri nüfusun aşılanması verilerinde 1’inci doz Türkiye ortalaması yüzde 92,70, 2’nci doz ortalaması yüzde 84,69 olarak ölçüldü. Ayrıca, 1’inci dozda 57 milyon 540 bin 072, 2’nci dozda 52 milyon 585 bin 057 ve 3’üncü dozda 25 milyon 978 bin 778 olmak üzere toplam 143 milyon 645 bin 420 aşı uygulandı.
En az 2 doz aşı olan kişi sayısının en yüksek olduğu iller; Osmaniye, Ordu, Amasya, Muğla, Kırklareli, Çanakkale, Eskişehir, Balıkesir, Zonguldak ve Manisa olurken, 2 doz aşı yapılan kişi sayısının en düşük olduğu iller ise Şanlıurfa, Batman, Siirt, Diyarbakır, Bingöl, Muş, Mardin, Bitlis, Ağrı ve Elazığ oldu.
Sağlık Bakanı Fahrettin Koca, Twitter hesabından yaptığı açıklamada, “Şanlıurfa, Diyarbakır, Batman, Siirt, Bingöl, Muş, Gaziantep, Mardin, Şırnak, Bitlis, Ağrı, Iğdır, Erzurum, Bayburt, Elazığ, Gümüşhane, Aksaray illerimizde ikinci doz oranları halen düşük. Artık hatırlatma dozu da gerekli olduğu halde! Daha fazla risk almayalım.” dedi.